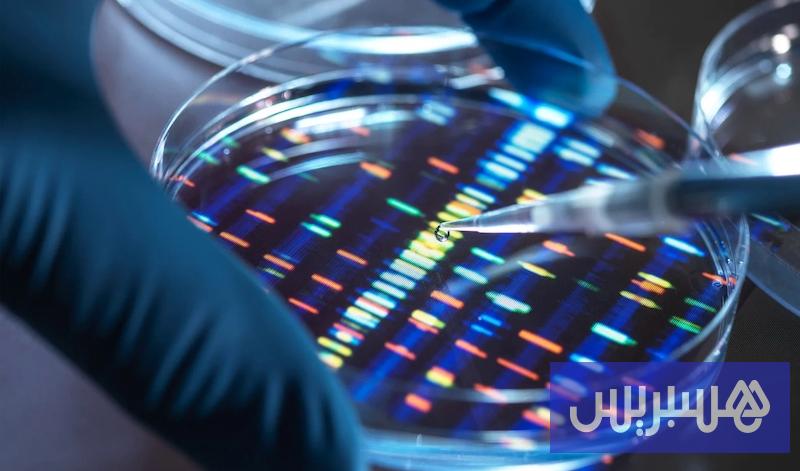

كشف فريق من الباحثين في “معهد برود” التابع لجامعة هارفارد عن نهج جديد في علاج الأمراض الوراثية النادرة، يقوم على استخدام تحرير الجينات بطريقة أكثر عمومية وقابلية للتطبيق على طيف واسع من الأمراض، بدلاً من الاقتصار على تصميم علاجات مخصصة لكل حالة على حدة، كما هو الحال حاليًا.
وقد نُشرت نتائج الدراسة في مجلة Nature العلمية، حيث قدّم العلماء ما وصفوه بأنه نهج “لا يرتبط بمرض بعينه”، ما يعني إمكانية تطوير علاج موحّد يمكن أن يخدم آلاف المرضى، بغض النظر عن نوع الطفرات الجينية التي يحملونها.
ونقلت صحيفة “نيويورك تايمز” عن البروفيسور ديفيد ر. ليو، كبير مؤلفي الدراسة، قوله: “نحن نتخلى عمدًا عن الفكرة الأكثر وضوحًا في علاج المرضى، وهي تصحيح الطفرة الوراثية لدى كل مريض على حدة”، مضيفًا أن ما يسعون إليه هو نهج يُمكن تطبيقه على مجموعات أكبر من المرضى، مما يسرّع العملية ويقلل من التكلفة.
في الولايات المتحدة وحدها، يعاني أكثر من 30 مليون شخص من أمراض وراثية نادرة تُعرّف بأنها تصيب أقل من 200 ألف شخص لكل مرض بينما يبلغ العدد عالميًا نحو 400 مليون شخص. ورغم أن الأمل يحدو الكثيرين بشأن علاجات الجينات، فإن تطوير كل علاج بشكل فردي يُعد أمرًا مكلفًا وغير عملي من الناحية التجارية، خاصة أن شركات الأدوية نادرًا ما تستثمر في علاجات موجهة لفئة صغيرة من المرضى لا يمكن استرداد تكاليف تطوير العلاج منهم.
الدراسة الجديدة تركزت على “الطفرات الكامنة في الشيفرة الجينية التي تضع علامة توقف مبكرة في إنتاج البروتين”، ما يؤدي إلى إنتاج بروتينات غير مكتملة لا تعمل بشكل صحيح، وتُعد سببًا في العديد من الأمراض النادرة. بدلًا من محاولة تصحيح كل طفرة، لجأ الباحثون إلى إدخال جزيئات مصممة لتحفيز الخلية على تجاهل “علامة التوقف” غير الطبيعية، ومواصلة إنتاج البروتين بشكل كامل.
جُربت هذه المقاربة في خلايا بشرية تحمل طفرات مرتبطة بأمراض مثل “تايساكس”، “داء باتن”، “التليف الكيسي”، و”داء نيمانبيك من النوع C1″، وكذلك في فئران معدلة وراثيًا لمحاكاة “متلازمة هيرلر”. وأظهرت النتائج أن البروتينات المعطوبة عادت للعمل بشكل كافٍ نظريًا لتخفيف أعراض هذه الأمراض.
وقد وصف الدكتور فيودور أورنوف، خبير تحرير الجينات في جامعة كاليفورنيا بيركلي، هذا النهج بأنه يمثل نقلة نوعية، قائلًا: “بدلًا من تحسين مصيدة الفئران، اخترعوا قطًا”. وأضاف أن هذه المقاربة تمثل استخدامًا مختلفًا تمامًا لأدوات تحرير الجينات، وقد تجعلها متاحة لعدد أكبر من المرضى.
ورغم الإشادة العلمية، أكّد الباحثون على أن هذه التقنية لا تزال بحاجة إلى اختبارات إضافية، فضلًا عن تحديات تتعلق بإيصال العلاج إلى الأنسجة المطلوبة، خاصة في حالات الأمراض التي تصيب الدماغ أو الرئتين، حيث تظل مسألة إيصال العلاج بيولوجيًا وعقاريًا معقدة.
اعتمد الباحثون على جزيء يُسمى الحمض النووي الريبوزي الناقل القامع (suppressor tRNA)، الذي يستطيع تجاوز علامة التوقف الخاطئة في الشيفرة الجينية. ومن خلال تقنية متقدمة تُدعى “التحرير الأساسي” (prime editing)، تمكن الفريق من إدراج هذا الجزيء داخل خلايا الجسم، مستبدلين به الحمض النووي الريبوزي الناقل غير النشط.
الدكتور ليو أوضح أن بعض المحاولات السابقة لإنتاج أدوية تعتمد على هذه الجزيئات فشلت بسبب الحاجة إلى جرعات متكررة، أو مخاطر التسمم. أما طريقتهم، المعروفة اختصارًا بـPERT، فتعتمد على تدخل جيني لمرة واحدة، دون الحاجة إلى تكرار الجرعات، وقد أثبتت، بحسب الدراسة، خلوها من التأثيرات الجانبية السلبية.
الدكتور ريتشارد ليفتون، رئيس جامعة روكفلر وعضو مجلس إدارة “روش للأدوية”، قدّر أن هذه الطريقة قد تفيد ما بين 10 إلى 15 في المئة من مرضى التليف الكيسي أو ضمور العضلات من نوع “دوشين”، وربما تُستخدم مستقبلًا مع أكثر من ربع مليون مريض بـ”مرض ستارغاردت”، و31 ألفًا يعانون من “الفينيل كيتون يوريا”.
ومع ذلك، حذّر الدكتور أورنوف من الإفراط في التفاؤل، قائلاً: “قبل أن نتمكن من الطيران بهذا المحرك الجديد، علينا أن نبتكر طائرة خاصة به”. وأضاف: “الآلاف من المرضى ينتظرون، لكن أمامنا طريق طويل قبل أن تصل هذه التقنية إلى العيادات”.
الدراسة ممولة من معاهد الصحة الوطنية الأميركية، ومؤسسات أكاديمية، وجاءت استجابة لحالة الإحباط التي تواجه الباحثين في إيصال تقنيات الجينات إلى المرضى، رغم التقدم الكبير في العلوم. وقد سبق للدكتور ليو أن أسّس شركات في هذا المجال لكنها فشلت في الاستمرار بسبب محدودية الجدوى التجارية لعلاج أمراض نادرة جدًا.
ويأمل ليو وفريقه أن يغيّر هذا النهج الجديد المشهد، من خلال تقليص الاعتماد على العلاجات المصممة خصيصًا لكل مريض، نحو حلول قابلة للتكرار والتعميم، مما يعزز من فرص تحويل التقدّم العلمي إلى علاج فعلي لعدد أكبر من المصابين بأمراض وراثية نادرة.
المصدر: هسبريس